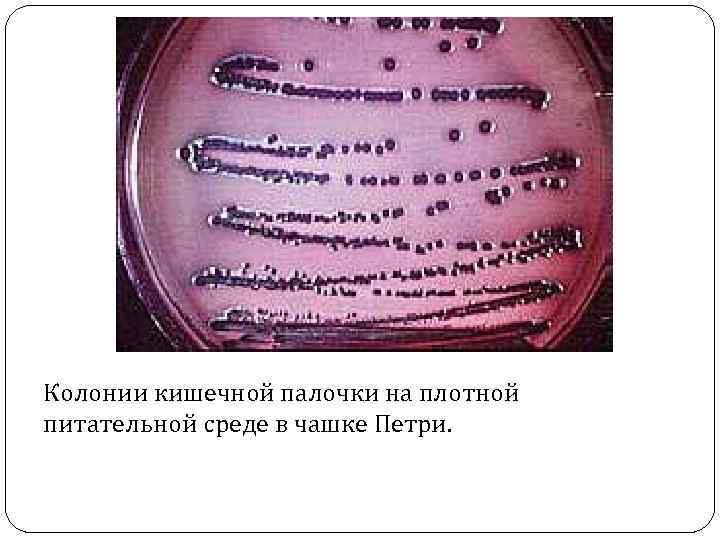
Колонии кишечной палочки на плотной питательной среде в чашке Петри.

3. Физиология и биохимия микроорганизмов.pptx
- Количество слайдов: 19

Основы микробиологии и иммунологии Физиология и биохимия микроорганизмов

Содержание: Химический состав бактерий. Питание, дыхание, рост и размножение бактерий. Ферменты и пигменты бактерий. Принципы культивирования микроорганизмов.

Химический состав бактерий По химическому составу микроорганизмы мало отличаются от других живых клеток: Вода составляет 75 -85% , в ней растворены химические вещества. Сухое вещество 15 -25%, в состав входят органические и минеральные соединения

Питание бактерий Поступление в бактериальную клетку питательных веществ осуществляется несколькими способами и зависит от концентрации веществ, величины молекул, р. Н среды, проницаемости мембран и др.

По типу питания микроорганизмы делятся на: автотрофы – синтезируют все углеродсодержащие вещества из СО 2; гетеротрофы – в качестве источника углерода используют органические вещества; сапрофиты – питаются органическими веществами отмерших организмов; паразиты – живу за счет органических веществ живой клетки.

Дыхание бактерий Дыхание, или биологическое окисление основано на окислительно-восстановительных реакциях, идущих с образованием молекулы АТФ.

По отношению к молекулярному кислороду бактерии можно разделить на три основные группы: облигатные аэробы – могут расти только при наличии кислорода; облигатные анаэробы – растут на среде без кислорода, который для них токсичен; факультативные анаэробы – могут расти как при кислороде, так и без него.

Рост и размножение бактерий Рост – увеличение размеров бактериальной клетки и воспроизведение всех её структур. Размножение – способность к самовоспроизведению, в результате чего увеличивается число особей в популяции. Большинство прокариот размножаются бинарным делением пополам, реже почкованием и фрагментацией.

Клетка делится пополам (фото слева - вначале внутреннее содержимое клетки делится пополам, затем образуется поперечная мембранная перегородка, синтезируется клеточная стенка, завершающая деление).

Бактерии, как правило, характеризуются высокой скоростью размножения. Время деления клетки у различных бактерий колеблется довольно в широких пределах: от 20 минут у кишечной палочки до 14 часов у микобактерий туберкулеза. На плотных питательных средах бактерии образуют скопления клеток, называемые колониями.
Колонии кишечной палочки на плотной питательной среде в чашке Петри.

На жидких средах рост бактерий характеризуется образованием пленки на поверхности, равномерным помутнением либо осадком.

Ферменты бактерий Важную роль в обмене веществ микроорганизмов играют ферменты. Ферменты – это белки, участвующие в обмене веществ. Они расщепляют различные субстраты и ускоряют химические реакции. Различают: эндоферменты – локализуются в цитоплазме клеток, катализируют обмен веществ внутри клетки; экзоферменты – выделяются клеткой в окружающую среду, расщепляют макромолекулы питательных веществ до простых соединений.

ферменты агрессии - разрушают ткань и клетки, обусловливая широкое распространение микробов и их токсинов в инфицированной ткани.

Биохимические свойства бактерий определяются составом ферментов: сахаролитические –расщепление углеводов; протеолитические – расщепление белков, липолитические – расщепление жиров, Набор ферментов у разных бактерий различен, что выявляется по конечным продуктам расщепления (образование щелочей, кислот, сероводорода, аммиака и др. ).

Пигменты бактерий Многие микроорганизмы в процессе своей жизнедеятельности синтезируют пигменты, различающиеся по цвету, химическому составу и растворимости. Если пигменты нерастворимы в воде, окрашивается только колонии микроба, растущая на питательной среде, а если растворимы - окрашивается и питательная среда. Цвет пигмента используется в качестве теста для идентификации пигментообразующих бактерий.

Пигменты обеспечивают: защиту от УФ радиации участвуют в реакциях синтеза обладают антибиотическим действием.

Принципы культивирования микроорганизмов

Большинство бактерий и грибов культивируются на естественных и искусственных, плотных и жидких питательных средах, в оптимальных для них условиях. На питательных средах микроорганизмы при размножении образуют определенной морфологии колонии, что определяет их культуральные свойства. Идентификацию бактерий в исследуемом материале проводят на основании определения морфологических, биохимических, культуральных и других свойств микроскопическими, микробиологическими и другими методами исследования.
3. Физиология и биохимия микроорганизмов.pptx